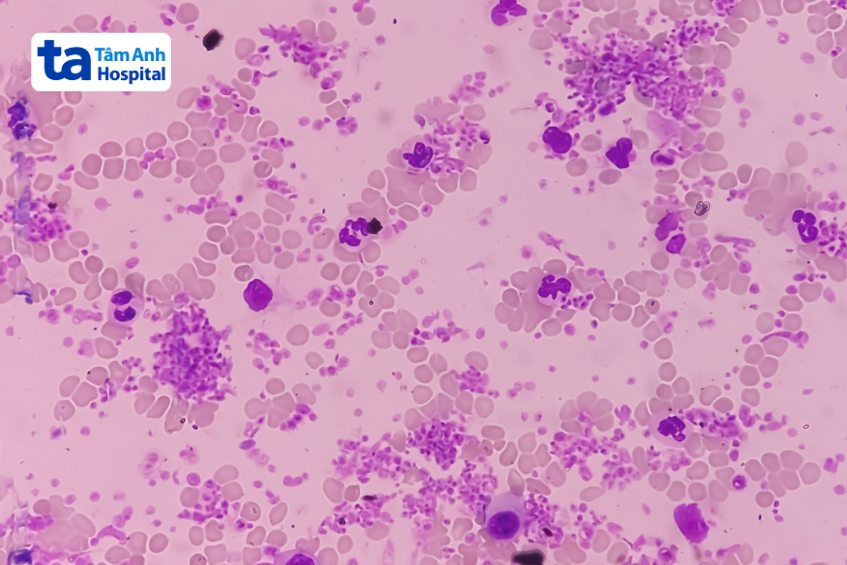
tế bào tiểu cầu tăng

Tăng tiểu cầu hay tiểu cầu tăng có thể ảnh hưởng đến sức khỏe của người bệnh. Vậy nguyên nhân gây tăng tiểu cầu máu là gì? Chẩn đoán và điều trị bệnh này như thế nào?

Tăng tiểu cầu (thrombocytosis) là tình trạng số lượng tiểu cầu trong máu vượt quá mức 450,000 tế bào / mcL (Cao hơn mức bình thường). Ở cơ thể khỏe mạnh, mỗi microlit máu (mcL) chứa khoảng từ 150,000 – 450,000 tế bào tiểu cầu.
Tiểu cầu là các tế bào nhỏ trong máu giúp đông máu và ngăn ngừa chảy máu. Khi số lượng tiểu cầu tăng quá mức có thể dẫn đến các vấn đề sức khỏe nghiêm trọng, bao gồm nguy cơ hình thành cục máu đông, đột quỵ, hoặc nhồi máu cơ tim [1]. Tùy thuộc vào mức độ tăng tiểu cầu trong máu, bác sĩ sẽ cân nhắc đưa ra phác đồ điều trị phù hợp.
Bệnh tăng tiểu cầu bao gồm hai phân loại là tăng tiểu cầu tiên phát (hay nguyên phát) và tăng tiểu cầu thứ phát, cụ thể:
Tăng tiểu cầu tiên phát là một rối loạn tủy xương mãn tính thuộc nhóm bệnh lý tăng sinh tủy. Đây là tình trạng tủy xương sản xuất quá nhiều tiểu cầu mà không có nguyên nhân rõ ràng hoặc liên quan đến sự đột gen. Biểu hiện của bệnh được đặc trưng bởi sự gia tăng số lượng tiểu cầu ở máu ngoại vi và mẫu tiểu cầu trong tủy xương, kèm theo một số biến chứng do tình trạng này gây nên.
Tăng tiểu cầu thứ phát hay còn gọi là tăng tiểu cầu phản ứng được đặc trưng bởi tình trạng tăng số lượng tế bào tiểu cầu xảy ra do sự ảnh hưởng của các tình trạng rối loạn, bệnh lý khác trong cơ thể.
Số lượng tiểu cầu ở người mắc bệnh này thường ít hơn 1,000,000 tế bào / mcL [2]. Bác sĩ có thể xác định được nguyên nhân gây bệnh từ quá trình thăm khám, kiểm tra bệnh sử và yêu cầu người bệnh thực hiện các xét nghiệm chuyên sâu nếu cần thiết. Khác với bệnh tăng tiểu cầu nguyên phát, bệnh lý này không tiềm ẩn biến chứng xuất huyết hay huyết khối (trừ trường hợp mắc bệnh động mạch vành).
Hiện nay, nguyên nhân khiến cho quá trình sản xuất mẫu tiểu cầu tăng cao bất thường, dẫn đến bệnh tăng tiểu cầu tiên phát vẫn chưa được xác định cụ thể. Trong một số trường hợp, nguyên nhân tiểu cầu tăng có thể liên quan đến sự xuất hiện các đột biến JAK2, CALR và MPL [3] trong cơ thể.
Bệnh lý này không phải là một rối loạn tủy xương nguyên phát mà là kết quả của các yếu tố ngoại lai tác động lên hệ thống tạo máu, đó có thể là rối loạn viêm nhiễm mạn tính (viêm đại tràng, viêm khớp dạng thấp…), nhiễm trùng cấp tính, thiếu sắt, sau cắt lách, bệnh ung thư… Ngoài ra, căn nguyên của bệnh lý này có thể đến từ tình trạng đột biến gen thrombopoietin.
Thông thường, bệnh lý này không biểu hiện triệu chứng rõ ràng, tuy nhiên trong một số trường hợp người bệnh có thể gặp phải các dấu hiệu như:

Trong một số trường hợp, người bệnh tăng tiểu cầu tiên phát có thể gây khởi phát chứng Erythromelalgia – tình trạng đau, sưng đỏ, ngứa râm ran ở chân và tay. Ngoài ra, khi bệnh tiến triển nghiêm trọng có thể dẫn đến hình thành huyết khối bất thường ở bụng (hội chứng Budd-Chiari) làm tăng nguy cơ đau tim hoặc đột quỵ.
Để chẩn đoán chính xác bệnh lý tăng tiểu cầu, người bệnh cần trải qua quá trình thăm khám lâm sàng để bác sĩ ghi nhận bệnh sử, triệu chứng đặc hiệu và các vấn đề liên quan. Sau đó, bác sĩ sẽ chỉ định người bệnh thực hiện một số xét nghiệm chuyên sâu để đánh giá được chính xác mức độ tăng tiểu cầu trong máu, bao gồm:
Sau khi chẩn đoán chính xác tình trạng tăng tiểu cầu, tùy vào nguyên nhân tăng tiểu cầu và mức độ của bệnh, bác sĩ sẽ đưa ra phác đồ điều trị phù hợp với từng trường hợp. Để theo dõi chặt chẽ tiến triển của bệnh, bác sĩ có thể sẽ yêu cầu người bệnh thực hiện xét nghiệm công thức máu định kỳ.
Thông thường, tình trạng tăng tiểu cầu thứ phát sẽ thuyên giảm sau khi căn nguyên gây bệnh được điều trị hiệu quả. Mặt khác, phác đồ điều trị bệnh tăng tiểu cầu tiên phát thường tập trung vào mục đích làm giảm lượng tiểu cầu và kiểm soát triệu chứng của bệnh, bao gồm:

Nếu không được chẩn đoán và điều trị kịp thời, tình trạng tăng tiểu cầu có thể dẫn đến nhiều biến chứng nguy hiểm, ảnh hưởng nghiêm trọng đến sức khỏe của người bệnh, bao gồm:
Chúng ta đã biết nguyên nhân làm tăng tiểu cầu. Để phòng ngừa tình trạng này, mỗi người có thể chủ động áp dụng một số cách như:

Bệnh tăng tiểu cầu có nguy hiểm không? Tăng tiểu cầu nếu không được điều trị kịp thời có thể tiềm ẩn nhiều biến chứng nguy hiểm cho sức khỏe của người bệnh. Bởi lẽ, bệnh tăng tiểu cầu tiên phát có thể dẫn đến hình thành huyết khối làm tăng nguy cơ đột quỵ, tắc nghẽn lưu lượng máu đến các cơ quan quan trọng trong cơ thể; tiềm ẩn nguy cơ gây xuất huyết, ảnh hưởng nghiêm trọng đến sức khỏe của người bệnh.
Trên thực tế, bệnh lý tăng tiểu cầu có thể xảy ra ở mọi đối tượng. Tuy vậy nguy cơ tăng tiểu cầu có thể gia tăng ở một số đối tượng như người nghiện thuốc lá, người mắc bệnh viêm nhiễm mạn tính, ung thư, đột biến gen thrombopoietin…
Tăng tiểu cầu có phải là ung thư máu? Bệnh tăng tiểu cầu tiên phát là bệnh thuộc nhóm tăng sinh ác tính, được xem như một dạng tiền ung thư máu. Tình trạng này thuộc nhóm hội chứng tăng sinh tuỷ, khiến tủy xương mất kiểm soát việc sản sinh tế bào tiểu cầu trong máu. Tuy nhiên, bệnh tăng tiểu cầu thứ phát không phải là bệnh ung thư máu. Để chẩn đoán chính xác tình trạng tiểu cầu tăng có phải là bệnh máu ác tính hay không, người bệnh cần sớm đến bệnh viện để bác sĩ trực tiếp thăm khám.
Các gen (như JAK2, CALR tạo ra protein calreticulin) bị đột biến khiến cho các tế bào gốc ở tủy xương tăng sản xuất tiểu cầu mất kiểm soát, dẫn đến bệnh tăng tiểu cầu tiên phát có thể di truyền. Trong khi đó, yếu tố di truyền của bệnh tăng tiểu cầu thứ phát đến từ các bệnh lý, rối loạn viêm nhiễm, tiềm ẩn nguy cơ làm số lượng tiểu cầu tăng cao.
Thăm khám và kiểm tra tình trạng tiểu cầu tại chuyên khoa Nội tổng hợp, BVĐK Tâm Anh vui lòng liên hệ:
HỆ THỐNG BỆNH VIỆN ĐA KHOA TÂM ANH
Như vậy, bài viết đã cung cấp những thông tin góp phần làm rõ các vấn đề về tình trạng tăng tiểu cầu. Về cơ bản, bệnh tăng tiểu cầu cần được chẩn đoán và điều trị kịp thời để tránh biến chứng nguy hiểm đe dọa sức khỏe của người bệnh. Nếu cần tư vấn về tình trạng tăng tiểu cầu là gì cũng như các vấn đề liên quan khác, người bệnh có thể liên hệ đến Hệ thống Bệnh viện Đa khoa Tâm Anh để được bác sĩ giải đáp chi tiết.